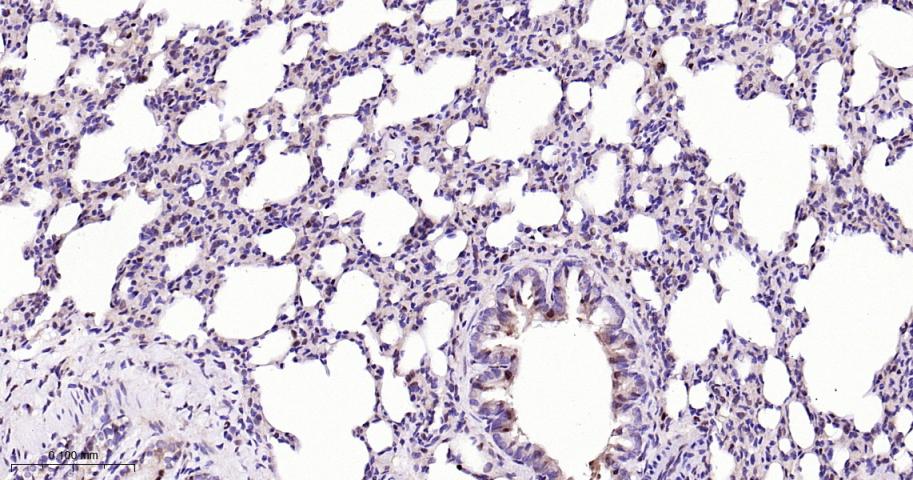
周期素依赖性激酶4重组兔单抗

周期素依赖性激酶4重组兔单抗
Rrmab?兔单抗

货号:bsm-63163R
产品详情
相关标记
相关产品
相关文献
常见问题
概述
产品编号
bsm-63163R
产品类型
重组兔单抗
英文名称
CDK4 Recombinant Rabbit mAb
中文名称
周期素依赖性激酶4重组兔单抗
英文别名
CMM3; PSK-J3; Crk3; CDK4_HUMAN; CDK4; Cell division protein kinase 4; 2.7.11.22; CDK4_MOUSE; CDK4_RAT;
抗体来源
Rabbit
免疫原
A synthesized peptide derived from human CDK4: 200-303
亚型
IgG
性状
Liquid
纯化方法
affinity purified by Protein A
克隆类型
Recombinant
克隆号
1F2
理论分子量
34 kDa
检测分子量
34 kDa
储存液
10mM phosphate buffered saline(pH 7.4) with 150mM sodium chloride, 0.05% BSA, 0.02% Proclin300 and 50% glycerol.
研究领域
SWISS
Gene ID
保存条件
Store at 4℃ for short term. Store at -20℃ for long term. Avoid repeated freeze/thaw cycles.
注意事项
This product as supplied is intended for research use only, not for use in human, therapeutic or diagnostic applications.
数据库链接
产品介绍
Cdk4为周期素依赖激酶4,主要参与细胞周期的调控,在细胞分化、有丝分裂中起重要作用。目前主要用于各种肿瘤的研究。
背景资料
Ser/Thr-kinase component of cyclin D-CDK4 (DC) complexes that phosphorylate and inhibit members of the retinoblastoma (RB) protein family including RB1 and regulate the cell-cycle during G1/S transition. Phosphorylation of RB1 allows dissociation of the transcription factor E2F from the RB/E2F complexes and the subsequent transcription of E2F target genes which are responsible for the progression through the G1 phase.

产品应用
| 应用 | 已检合格种属 | 预测种属 | 推荐稀释比例 |
|---|---|---|---|
| WB | Human, Mouse, Rat | 1:500-2000 | |
| IHC-P | Human, Mouse, Rat | 1:50-200 | |
| IHC-F | Human, Mouse, Rat | 1:50-200 | |
| IF | Human, Mouse, Rat | 1:50-200 | |
| Flow-Cyt | Human | Mouse, Rat | 1:50-100 |
| ICC/IF | Human | Mouse, Rat | 1:50-200 |
| IP | Human, Mouse, Rat | 1:20-50 |
交叉反应
交叉反应: Human, Mouse, Rat
相关产品
暂无相关产品
靶标
基因名
CDK4
蛋白名
Cyclin-dependent kinase 4 Cyclin-dependent kinase 4
亚基
Component of the D-CDK4 complex, composed of CDK4 and some D-type G1 cyclin (CCND1, CCND2 or CCND3). Interacts directly in the complex with CCND1, CCND2 or CCND3. Interacts with SEI1 and ZNF655. Forms a ternary complex, cyclin D-CDK4-CDKN1B, involved in modulating CDK4 enzymatic activity. Interacts directly with CDKN1B (phosphorylated on 'Tyr-88' and 'Tyr-89'); the interaction allows assembly of the cyclin D-CDK4 complex, Thr-172 phosphorylation, nuclear translocation and enhances the cyclin D-CDK4 complex activity. CDK4 activity is either inhibited or enhanced depending on stoichiometry of complex. The non-tyrosine-phosphorylated form of CDKN1B prevents T-loop phosphorylation of CDK4 producing inactive CDK4. Interacts (unphosphorylated form) with CDK2. Also forms ternary complexes with CDKN1A or CDKN2A. Interacts directly with CDKN1A (via its N-terminal); the interaction promotes the assembly of the cyclin D-CDK4 complex, its nuclear translocation and promotes the cyclin D-dependent enzyme activity of CDK4.
亚细胞定位
Cytoplasm. Nucleus. Membrane. Cytoplasmic when non-complexed. Forms a cyclin D-CDK4 complex in the cytoplasm as cells progress through G(1) phase. The complex accumulates on the nuclear membrane and enters the nucleus on transition from G(1) to S phase. Also present in nucleoli and heterochromatin lumps. Colocalizes with RB1 after release into the nucleus.
翻译后修饰
Phosphorylation at Thr-172 is required for enzymatic activity. Phosphorylated, in vitro, at this site by CCNH-CDK7, but, in vivo, appears to be phosphorylated by a proline-directed kinase. In the cyclin D-CDK4-CDKN1B complex, this phosphorylation and consequent CDK4 enzyme activity, is dependent on the tyrosine phosphorylation state of CDKN1B. Thus, in proliferating cells, CDK4 within the complex is phosphorylated on Thr-172 in the T-loop. In resting cells, phosphorylation on Thr-172 is prevented by the non-tyrosine-phosphorylated form of CDKN1B.
疾病
Defects in CDK4 are a cause of susceptibility to cutaneous malignant melanoma type 3 (CMM3) [MIM:609048]. Malignant melanoma is a malignant neoplasm of melanocytes, arising de novo or from a pre-existing benign nevus, which occurs most often in the skin but also may involve other sites.
相似性
Belongs to the protein kinase superfamily. CMGC Ser/Thr protein kinase family. CDC2/CDKX subfamily.
Contains 1 protein kinase domain.
功能
Ser/Thr-kinase component of cyclin D-CDK4 (DC) complexes that phosphorylate and inhibit members of the retinoblastoma (RB) protein family including RB1 and regulate the cell-cycle during G(1)/S transition. Phosphorylation of RB1 allows dissociation of the transcription factor E2F from the RB/E2F complexes and the subsequent transcription of E2F target genes which are responsible for the progression through the G(1) phase. Hypophosphorylates RB1 in early G(1) phase. Cyclin D-CDK4 complexes are major integrators of various mitogenenic and antimitogenic signals. Also phosphorylates SMAD3 in a cell-cycle-dependent manner and represses its transcriptional activity. Component of the ternary complex, cyclin D/CDK4/CDKN1B, required for nuclear translocation and activity of the cyclin D-CDK4 complex.
标记抗体
暂无标记数据
同靶标产品
暂无同靶标产品
相关文献
提示: 发表研究结果有使用 bsm-63163R 时请让我们知道,以便我们可以引用参考文章。作为回馈,资料提供者将获得我们送上的小礼品。
暂无相关文献
常见问题
暂无常见问题